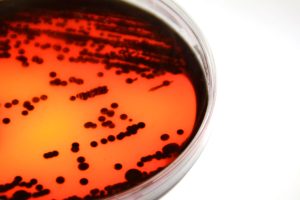
IST__photos__DSC2607

Internships
The participation of doctoral students in internships in industry and at foreign research institutes is a crucial element of doctoral training at Técnico.
Engaging in industry internships (e.g., at industrial companies, hospitals, public or private institutions) during the doctoral programme offers numerous advantages.
Firstly, it enhances the connection between academia and industry through the development of research projects that have potential interest to the companies. Secondly, it provides students with practical industry experience, which can encourage alternative career paths outside academia after completing their doctorate.
Promoting the mobility of doctoral students to follow internships at foreign research institutes is essential for the success of the PhD. This practice is already embedded in the scientific culture of Técnico’s research centers.